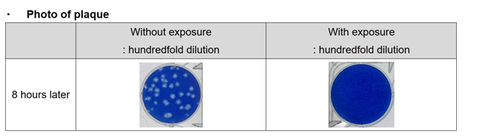

Världens första*1 verifierade hämmande effekt av Panasonics nanoe™ (elektrostatisk atomiserad vattenpartikel i nanostorlek) på vidhäftande nya coronavirus i ett testutrymme på 24 m3
Världens första*1 verifierade hämmande effekt av Panasonics nanoe™ (elektrostatisk atomiserad vattenpartikel i nanostorlek) på vidhäftande nya coronavirus i ett testutrymme på 24 m3
OSAKA, Japan--(BUSINESS WIRE)--Panasonic Corporation tillkännagav idag att företaget, i samarbete med Japan Textile Products Quality Technology Center, har verifierat den hämmande effekten av nanoe™ på det nya coronaviruset som vidhäftar i ett 24 m3 testutrymme. Det här är första gången i världshistorien som den hämmande effekten på vidhäftande coronavirus har bekräftats i ett testutrymme nästan lika stort som en vanlig rumsyta.
nanoe™ är en teknik som samlar upp osynlig fukt i luften och tillför högspänning för att producera ”hydroxylradikaler i vatten”. Hydroxylradikaler hämmar tillväxten av förorenande ämnen såsom bakterier och virus. De karakteriseras av att de är starkt oxidativa och mycket reaktiva, och därför har en kort livslängd. I små vattenpartiklar har nanoe™ en lång livslängd och kan spridas över hela utrymmet i ett rum. Den har en hämmande effekt på både luftburna och vidhäftade ämnen.
Mutationen av aminosyran i spike-proteinet har orsakat nya variantstammar med olika smittsamhet, överförbarhet och antigenicitet, såsom ökad bindningskapacitet till celler och minskad bindning till neutraliserande antikroppar. Den globala spridningen av det nya coronaviruset visar till följd av detta inga tecken på att avta. Forskning pågår för att identifiera egenskaperna hos den nuvarande dominerande Omicron-stammen, men ökningen av sekundära infektioner i hushåll och andra faktorer tyder på att dess infektionsförmåga har ökat jämfört med konventionella stammar, samt att ytterligare infektionsförebyggande åtgärder är av avgörande betydelse.
Vad beträffar nanoe™-teknologin verifierade Panasonic den hämmande effekten på det nya coronaviruset (SARS-CoV-2)*2 i juli 2020 och dess hämmande effekt på fyra nya varianter av coronavirus*3 i november 2021. Resultaten av de tidigare testerna utfördes i ett litet testutrymme på 45 liter.
Därför genomförde Panasonic ett jämförande experiment i ett 24 m3 stort testutrymme för att jämföra virustitrar med och utan exponering för nanoe™. En bit gasväv mättad med Deltastammen av det nya coronaviruset exponerades för nanoe™ i 8 timmar, och den hämmande effekten på över 99 % bekräftades. Notera att bekräftelseresultaten baseras på ett test i en sluten testmiljö och inte i ett utrymme som faktiskt används.
Panasonic kommer att fortsätta utnyttja potentialen hos nanoe™ och bidra till samhället genom att tillhandahålla tryggare och säkrare utrymmen.
・ För referens
Test av den hämmande effekten av nanoe-teknik bekräftad på det vidhäftade nya coronavirusets Deltavariant (SARS-CoV-2) i ett testutrymme på cirka 24 m3
・ Översikt
En jämförande verifiering genomfördes i ett 24 m3 stort testutrymme innehållande det nya coronavirusets Deltavariant (SARS-CoV-2)
・ Resultat
Minskningen av virusinfektionstitrar på mer än 99 % mot den vidhäftade, nya Deltacoronavirusvarianten (SARS-CoV-2) med nanoe™-tekniken verifierades också i ett 24 m3 stort testutrymme.
Observera! Denna verifiering gjordes för att generera grundläggande forskningsdata om effekterna av nanoe™ på det nya coronaviruset i laboratorieförhållanden som skiljer sig från de som finns i vanliga boendemiljöer.
・ Resultatdata
Testobjekt |
Tid |
Inhiberingsgrad |
Vidhäftande ny Delta coronavirusvariant (SARS-CoV-2) |
8 timmar |
99,8 % |
・ Metodik och data
Organisation :Japan Textile Products Quality and Technology Center (QTEC)
Ämne: Vidhäftande ny Deltacoronavirusvariant (SARS-CoV-2)
Utrustning :nanoe™-enhet
Metod:
► I ett testutrymme på 24 m3, (2700mm x 3640mm x 2450mm) placeras en bit gasväv mättad med viruslösningen på en plats 1,5 m från nanoe™-generatorn, 1,2 m från golvet samt exponerad för nanoe™ (utspritt in i testutrymmet genom luftflöde från en fläkt installerad på väggen).*4
► Virusinfektionstitern mäts och hämningsgraden beräknas*5
・ Princip för generering av hydroxylradikaler
Atomiseringselektroden kyls av ett Peltier-element, som kondenserar fukt i luften för att framställa vatten. Därefter appliceras en hög spänning över atomiseringen och motelektroderna för att generera "hydroxylradikaler som finns i vatten" på ca. 5 till 20 nm storlek.
*1 Beträffande luftreningsteknik av jonemissionstyp (från och med 1 mars 2022, undersökt av Panasonic)
*2 Verifiering av den hämmande effekten av hydroxylradikaler i vatten på det nya coronaviruset (SARS-CoV-2) (Presenterad i juli 2020)
*3 Verifiering av den hämmande effekten av nanoteknologin på fyra befarade mutantstammar av det nya coronaviruset (släpptes i november 2021). Titern på det nya coronaviruset och de fyra mutantstammarna visade samma sjunkande trend oavsett stam. Samma resultat kan förväntas för mutanta stammar som kan uppstå i framtiden om de testas under samma förhållanden i 45L.
*4 Baserat på "Testmetod för att utvärdera luftrenares prestanda för att hämma virus som fastnar inomhus (upprättad den 4 juli 2011)" specificerad av Japan Electrical Manufacturers' Association
*5 Beräknat av Panasonic
Om Panasonic
Panasonic Corporation är en globalt ledande utvecklare av innovativa teknologier och lösningar för breda applikationer inom hemelektronik, bostäder, fordon och B2B-sektorer. Företaget, som firade 100-årsjubileum 2018, har expanderat globalt och driver nu 522 dotterbolag och 69 intressebolag över hela världen samt registrerade en konsoliderad nettoomsättning på 6,698,8 biljoner yen för året som avslutades 31 mars 2021. Företaget har åtagit sig att sträva efter nya värden genom innovation på olika nivåer och använder sin teknik för att skapa ett bättre liv och en bättre värld för sina kunder. Läs mer om Panasonic här: https://www.panasonic.com/global
# # #
Detta meddelandes ursprungliga källspråkstext är den officiella versionen. Översättningar tillhandahålls endast som ett stöd och skall jämföras med källspråkstexten, vilken är den enda versionen av texten som har rättslig verkan.
Contacts
Presskontakt:
Tanya Houston, Wildwood PR tanya.houston@wildwoodpr.com